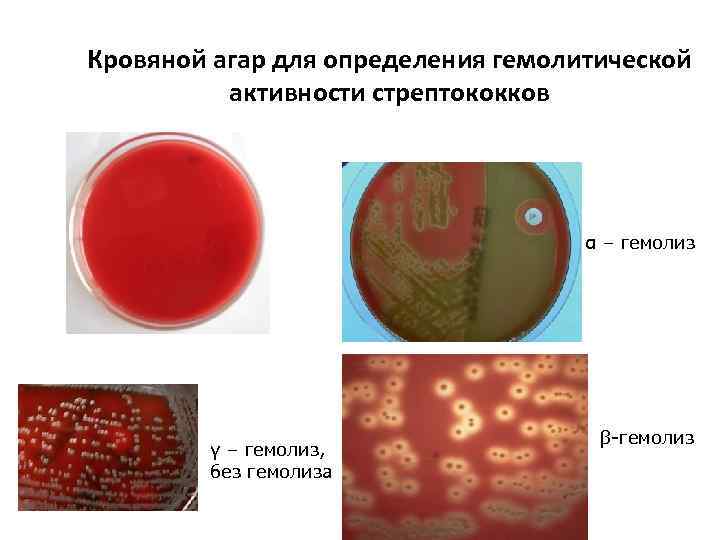

2015Стрептококки Гр(+).ppt
- Количество слайдов: 46
 Род Streptococcus
Род Streptococcus
 Патогенные стрептококки • План • • • 1. Заболевания 2. Новые инвазивные формы стрептококковой инфекции 3. Таксономия и систематика 4. Классификация 5. Морфологические свойства 6. Культуральные и биохимические свойства 7. Факторы патогенности 8. Антигенные свойства. Классификация. 9. Лабораторная диагностика 10. Чувствительность к антимикробным препаратам
Патогенные стрептококки • План • • • 1. Заболевания 2. Новые инвазивные формы стрептококковой инфекции 3. Таксономия и систематика 4. Классификация 5. Морфологические свойства 6. Культуральные и биохимические свойства 7. Факторы патогенности 8. Антигенные свойства. Классификация. 9. Лабораторная диагностика 10. Чувствительность к антимикробным препаратам
 Представители рода Streptococcus • Заболевания, вызываемые представителями рода Streptococcus, известны с глубокой древности, но пика заболеваемости они достигли в XVIII--XIX веке. На этот период пришлись известные эпидемии скарлатины, фарингитов, нередко заканчивавшиеся пневмониями, ревматизмом и гломерулонефритами. • Постоянными спутниками войн были часто фатальные инфекции кожи и мягких тканей. • Жертвами послеродового сепсиса, печально известного как «родильная горячка» , стали сотни тысяч матерей.
Представители рода Streptococcus • Заболевания, вызываемые представителями рода Streptococcus, известны с глубокой древности, но пика заболеваемости они достигли в XVIII--XIX веке. На этот период пришлись известные эпидемии скарлатины, фарингитов, нередко заканчивавшиеся пневмониями, ревматизмом и гломерулонефритами. • Постоянными спутниками войн были часто фатальные инфекции кожи и мягких тканей. • Жертвами послеродового сепсиса, печально известного как «родильная горячка» , стали сотни тысяч матерей.
 История открытия • В тканях человека стрептококки впервые были обнаружены известным хирургом Теодором Бильротом при роже и раневых инфекциях в 1874 г. Именно Бильрот впервые назвал их стрептококками (от греч. «streptos» -цепочка и «coccus» - ягода). • В 1878 г. эти бактерии заметил Луи Пастер, изучая явление послеродового сепсиса. • Выделить чистую культуру стрептококков впервые удалось только Ф. Фелейзену в 1883 г. • На сегодняшний день известно, что стрептококки могут поражать практически любую часть тела. • Выделяют стрептококки патогенные для человека. • Некоторые из них являются сапрофитами молока и других продуктов. • Род Streptococcus включает и непатогенные виды.
История открытия • В тканях человека стрептококки впервые были обнаружены известным хирургом Теодором Бильротом при роже и раневых инфекциях в 1874 г. Именно Бильрот впервые назвал их стрептококками (от греч. «streptos» -цепочка и «coccus» - ягода). • В 1878 г. эти бактерии заметил Луи Пастер, изучая явление послеродового сепсиса. • Выделить чистую культуру стрептококков впервые удалось только Ф. Фелейзену в 1883 г. • На сегодняшний день известно, что стрептококки могут поражать практически любую часть тела. • Выделяют стрептококки патогенные для человека. • Некоторые из них являются сапрофитами молока и других продуктов. • Род Streptococcus включает и непатогенные виды.
 Таксономия рода Streptococcus Отдел Firmicutes Семейство Streptococcaceae Род Streptococcus • Род включает в себя около 29 видов
Таксономия рода Streptococcus Отдел Firmicutes Семейство Streptococcaceae Род Streptococcus • Род включает в себя около 29 видов
 Морфология • Стрептококки – Гр(+) клетки шаровидной или овоидной формы диаметром 0, 5 -1, 0 мкм, редко с заостренными концами до 1, 5 мкм • Диплококки!!!!!!! • Растут в виде цепочек различной длины. Длинные цепочки насчитывают до 50 и более клеток, короткие 4 -10. • Клеточная стенка содержит тейхоевые кислоты, углеводы и пептидогликаны, на её поверхности расположены фимбрии (чаще обнаруживают в колониях). • Патогенные штаммы образуют капсулу (обычно в организме человека), однако этот признак не является постоянным. • Как правило, стрептококки неподвижны (кроме некоторых представителей серогруппы D). • Спор не образуют. • Одной из наиболее ярких характерных особенностей стрептококков является отсутствие каталазной активности и способность большинства видов лизировать эритроциты. • Стрептококки - факультативные анаэробы, но имеются и строгие анаэробы. • Температурный оптимум 37°С, но могут расти и при температуре от 15°С до 45°С. • Оптимальная р. Н среды 7, 2 -7, 6.
Морфология • Стрептококки – Гр(+) клетки шаровидной или овоидной формы диаметром 0, 5 -1, 0 мкм, редко с заостренными концами до 1, 5 мкм • Диплококки!!!!!!! • Растут в виде цепочек различной длины. Длинные цепочки насчитывают до 50 и более клеток, короткие 4 -10. • Клеточная стенка содержит тейхоевые кислоты, углеводы и пептидогликаны, на её поверхности расположены фимбрии (чаще обнаруживают в колониях). • Патогенные штаммы образуют капсулу (обычно в организме человека), однако этот признак не является постоянным. • Как правило, стрептококки неподвижны (кроме некоторых представителей серогруппы D). • Спор не образуют. • Одной из наиболее ярких характерных особенностей стрептококков является отсутствие каталазной активности и способность большинства видов лизировать эритроциты. • Стрептококки - факультативные анаэробы, но имеются и строгие анаэробы. • Температурный оптимум 37°С, но могут расти и при температуре от 15°С до 45°С. • Оптимальная р. Н среды 7, 2 -7, 6.
 Род Streptococcus (цепочки клеток)
Род Streptococcus (цепочки клеток)
 Цепочки Streptococcus sp.
Цепочки Streptococcus sp.
 Морфологические и тинкториальные свойства Streptococcus sp. Световая микроскопия. Окраска по Граму
Морфологические и тинкториальные свойства Streptococcus sp. Световая микроскопия. Окраска по Граму
 Культивирование на жидких ПС 1. На жидких питательных средах S. pyogenes дает придонно-пристеночный рост с образованием мелкозернистого осадка и сохранением полной прозрачности среды. 2. S. bovis и некоторые штаммы S. pyogenes и S. agalactiae вызывают интенсивное помутнение бульона с образованием небольшого гомогенного осадка. 2 1
Культивирование на жидких ПС 1. На жидких питательных средах S. pyogenes дает придонно-пристеночный рост с образованием мелкозернистого осадка и сохранением полной прозрачности среды. 2. S. bovis и некоторые штаммы S. pyogenes и S. agalactiae вызывают интенсивное помутнение бульона с образованием небольшого гомогенного осадка. 2 1
 Морфология колоний стрептококков на плотных ПС • Очень мелкие колонии – 0, 5 -1 мм в диаметре • Полупрозрачные беловато-сероватые "росинки"
Морфология колоний стрептококков на плотных ПС • Очень мелкие колонии – 0, 5 -1 мм в диаметре • Полупрозрачные беловато-сероватые "росинки"
 Культуральные и биохимические свойства Streptococcus sp. • Хорошо растут на средах с добавлением крови (МПА + 5 -7% крови) • Факультативные анаэробы • (O/F-тест - +/+) • Каталаза (–) (главный дифференцирующий тест от стафилококков) • Оптимальная t° роста 37°С • р. Н 7, 6 -7, 8 • Хорошо выносят высыхание в белковом окружении (кровь, гной) • В ЖПС – пристеночно-придонный рост (т. к. образуют цепочки)
Культуральные и биохимические свойства Streptococcus sp. • Хорошо растут на средах с добавлением крови (МПА + 5 -7% крови) • Факультативные анаэробы • (O/F-тест - +/+) • Каталаза (–) (главный дифференцирующий тест от стафилококков) • Оптимальная t° роста 37°С • р. Н 7, 6 -7, 8 • Хорошо выносят высыхание в белковом окружении (кровь, гной) • В ЖПС – пристеночно-придонный рост (т. к. образуют цепочки)
 Таксономия и систематика рода Streptococcus • • • S. pyogenes S. agalactiae S. pneumoniae S. faecalis (Enterococcus faecalis) S. lactis (Lactococcus lactis)
Таксономия и систематика рода Streptococcus • • • S. pyogenes S. agalactiae S. pneumoniae S. faecalis (Enterococcus faecalis) S. lactis (Lactococcus lactis)
 Типы классификации стрептококков: • - по типу гемолиза (классификация Брауна) • - по серологическим свойствам (классификация Лансфилд ) • - общепринятыми названиями наряду с латинскими родовыми и видовыми
Типы классификации стрептококков: • - по типу гемолиза (классификация Брауна) • - по серологическим свойствам (классификация Лансфилд ) • - общепринятыми названиями наряду с латинскими родовыми и видовыми
 Классификация стрептококков по способности к гемолизу (классификация Брауна (1919)) • • • α-гемолитические: дают на кровяном агаре неполный гемолиз в виде полупрозрачной зоны зеленоватого оттенка в результате перехода гемоглобина в метгемоглобин, поэтому α-гемолитические стрептококки еще называют зеленящими стрептококками. Зеленящие стрептококки дают мелкие 1 -1, 5 мм диаметром колонии сероватого цвета с гладкой и шероховатой поверхностью. Такие колонии характерны для многих видов, вегетирующих на слизистой оболочке полости рта (S. salivarius, S. mutants, S. oralis и др. ). Они не взаимодействуют с групповыми сыворотками по Лэнсфилд. ассоциируются с вялотекущим хроническим процессом (инфекция синусов или одонтогенные абсцессы), однако они могут вызывать и более тяжелые процессы, например, подострый бактериальный эндокардит. • β-гемолитические: дают полное просветление среды вокруг колоний (полный лизис эритроцитов) полный гемолиз (S. agalactiae, S. pyogenes) являются более вирулентными и ассоциируются с острой воспалительной реакцией; • γ-гемолитические: не разрушают эритроциты, непатогенны для человека.
Классификация стрептококков по способности к гемолизу (классификация Брауна (1919)) • • • α-гемолитические: дают на кровяном агаре неполный гемолиз в виде полупрозрачной зоны зеленоватого оттенка в результате перехода гемоглобина в метгемоглобин, поэтому α-гемолитические стрептококки еще называют зеленящими стрептококками. Зеленящие стрептококки дают мелкие 1 -1, 5 мм диаметром колонии сероватого цвета с гладкой и шероховатой поверхностью. Такие колонии характерны для многих видов, вегетирующих на слизистой оболочке полости рта (S. salivarius, S. mutants, S. oralis и др. ). Они не взаимодействуют с групповыми сыворотками по Лэнсфилд. ассоциируются с вялотекущим хроническим процессом (инфекция синусов или одонтогенные абсцессы), однако они могут вызывать и более тяжелые процессы, например, подострый бактериальный эндокардит. • β-гемолитические: дают полное просветление среды вокруг колоний (полный лизис эритроцитов) полный гемолиз (S. agalactiae, S. pyogenes) являются более вирулентными и ассоциируются с острой воспалительной реакцией; • γ-гемолитические: не разрушают эритроциты, непатогенны для человека.
Кровяной агар для определения гемолитической активности стрептококков α – гемолиз γ – гемолиз, без гемолиза β-гемолиз
Кровяной агар для определения гемолитической активности стрептококков α – гемолиз γ – гемолиз, без гемолиза β-гемолиз
 Классификация стрептококков по степени резистентности к физико-химическим факторам • 1. рост при температуре 45°С и 10°С • 2. способность роста на среде с 40% желчи • 3. способность роста на среде с 6, 5% Na. Cl
Классификация стрептококков по степени резистентности к физико-химическим факторам • 1. рост при температуре 45°С и 10°С • 2. способность роста на среде с 40% желчи • 3. способность роста на среде с 6, 5% Na. Cl
 Классификация стрептококков по совокупности признаков : 1. 2. 3. 4. 5. Гноеродно-гемолитические Стоматические (ротовой полости) Энтерококки (Enterococcus faecalis) Молочнокислые (Lactococcus lactis) Анаэробные кокки
Классификация стрептококков по совокупности признаков : 1. 2. 3. 4. 5. Гноеродно-гемолитические Стоматические (ротовой полости) Энтерококки (Enterococcus faecalis) Молочнокислые (Lactococcus lactis) Анаэробные кокки
 Серологическая классификация Ребекки Лэнсфилд, По АГ различиям ПС и Б клеточной стенки делят на 21 серогруппу (от А до V): • Стрептококки серогруппы А (S. pyogenes ) • Стрептококки серогруппы В (S. agalactiae) • Стрептококки серогруппы С и G (S. equi, S. zooepidermicus) • Стрептококки серогруппы D (В основном – энтерококки) • Стрептококки, не содержащие групповой АГ (зеленящие и пневмококки) (S. mutans, S. pneumoniae)
Серологическая классификация Ребекки Лэнсфилд, По АГ различиям ПС и Б клеточной стенки делят на 21 серогруппу (от А до V): • Стрептококки серогруппы А (S. pyogenes ) • Стрептококки серогруппы В (S. agalactiae) • Стрептококки серогруппы С и G (S. equi, S. zooepidermicus) • Стрептококки серогруппы D (В основном – энтерококки) • Стрептококки, не содержащие групповой АГ (зеленящие и пневмококки) (S. mutans, S. pneumoniae)
 Особые АГ свойства стрептококков • M-Белок - основной поверхностный антиген стрептококков группы A Известно более 100 вариантов этого белка, каждый из которых свойственен определенному серотипу бактерии, то есть служит типоспецифическим антигеном. Белок М обеспечивает устойчивость стрептококков группы A к фагоцитозу в крови человека. Очевидно, он связывает фибриноген , тем самым препятствуя активации комплемента и опсонизации фрагментами комплемента бактериальных клеток. Белок М термоустойчив в кислой среде, но разрушается трипсином и пепсином. Его обнаруживают после солянокислого гидролиза стрептококков с помощью реакции преципитации. Белок Т разрушается при нагревании в кислой среде, но устойчив к действию трипсина и пепсина. Его определяют с помощью реакции агглютинации. По Т-белку стрептококки серогруппы А также подразделяют на несколько десятков серовариантов. R-антиген обнаружен также у стрептококков серогрупп В, С и D. Он чувствителен к пепсину, но не к трипсину, разрушается при нагревании в присутствии кислоты, но устойчив при умеренном нагревании в слабом щелочном растворе. Роль Т- и R-белков изучена мало. Стрептококки также имеют перекрестно реагирующие антигены, общие антигенам клеток базального слоя эпителия кожи и эпителиальных клеток корковой и медуллярной зон тимуса, что, возможно, является причиной аутоиммунных нарушений, вызываемых этими кокками. В клеточной стенке стрептококков обнаружен антиген (рецептор II), с которым связана их способность, как и стафилококков, имеющих белок А, взаимодействовать с Fc-фрагментом молекулы Ig. G.
Особые АГ свойства стрептококков • M-Белок - основной поверхностный антиген стрептококков группы A Известно более 100 вариантов этого белка, каждый из которых свойственен определенному серотипу бактерии, то есть служит типоспецифическим антигеном. Белок М обеспечивает устойчивость стрептококков группы A к фагоцитозу в крови человека. Очевидно, он связывает фибриноген , тем самым препятствуя активации комплемента и опсонизации фрагментами комплемента бактериальных клеток. Белок М термоустойчив в кислой среде, но разрушается трипсином и пепсином. Его обнаруживают после солянокислого гидролиза стрептококков с помощью реакции преципитации. Белок Т разрушается при нагревании в кислой среде, но устойчив к действию трипсина и пепсина. Его определяют с помощью реакции агглютинации. По Т-белку стрептококки серогруппы А также подразделяют на несколько десятков серовариантов. R-антиген обнаружен также у стрептококков серогрупп В, С и D. Он чувствителен к пепсину, но не к трипсину, разрушается при нагревании в присутствии кислоты, но устойчив при умеренном нагревании в слабом щелочном растворе. Роль Т- и R-белков изучена мало. Стрептококки также имеют перекрестно реагирующие антигены, общие антигенам клеток базального слоя эпителия кожи и эпителиальных клеток корковой и медуллярной зон тимуса, что, возможно, является причиной аутоиммунных нарушений, вызываемых этими кокками. В клеточной стенке стрептококков обнаружен антиген (рецептор II), с которым связана их способность, как и стафилококков, имеющих белок А, взаимодействовать с Fc-фрагментом молекулы Ig. G.
 Факторы патогенности Streptococcus sp. • Первый этап инфекционного процесса – адгезия на эпителий слизистых оболочек. • Основные адгезины стрептококков : 1. липотейхоевые кислоты, покрывающие поверхностные фимбрии. 2. гиалуронидаза и стрептокиназа - основные факторы патогенности стрептококков.
Факторы патогенности Streptococcus sp. • Первый этап инфекционного процесса – адгезия на эпителий слизистых оболочек. • Основные адгезины стрептококков : 1. липотейхоевые кислоты, покрывающие поверхностные фимбрии. 2. гиалуронидаза и стрептокиназа - основные факторы патогенности стрептококков.
 Факторы патогенности Streptococcus sp. поверхностные структуры • Белок М (от англ. «mucoid» - слизистый, так колонии штаммов-продуцентов имеют слизистую консистенцию) - главный фактор патогенности. М-белки стрептококка представляют собой фибриллярные молекулы, которые образуют фимбрии на поверхности клеточной стенки стрептококков группы А. М-белок определяет адгезивные свойства, угнетает фагоцитоз, определяет антигенную типоспецифичность и обладает свойствами суперантигена. Антитела к М-антигену обладают защитными свойствами (антитела к Т- и Rбелкам такими свойствами не обладают). М- подобные белки обнаружены у стрептококков групп С и G. Возможно, они являются для них факторами патогенности. • Капсула - второй по значимости фактор вирулентности. Она защищает бактерии от антимикробного потенциала фагоцитов и облегчает адгезию к эпителию. В ее состав входит гиалуроновая кислота, аналогичной той, которая входит в состав ткани человека, поэтому фагоциты не распознают стрептококки, имеющие капсулу, как чужеродные антигены. Капсула маскирует от них стрептококки. Интерес представляет способность бактерий самостоятельно разрушать капсулу при инвазии в ткани за счёт синтеза гиалуронидазы. Роль гиалуронидазы в патогенезе поражений изучена плохо: с одной стороны, она участвует в разрушении соединительнотканной стромы, с другой -- имеет сходство со многими аутоантигенами и, возможно, участвует в запуске аутоиммунных реакций.
Факторы патогенности Streptococcus sp. поверхностные структуры • Белок М (от англ. «mucoid» - слизистый, так колонии штаммов-продуцентов имеют слизистую консистенцию) - главный фактор патогенности. М-белки стрептококка представляют собой фибриллярные молекулы, которые образуют фимбрии на поверхности клеточной стенки стрептококков группы А. М-белок определяет адгезивные свойства, угнетает фагоцитоз, определяет антигенную типоспецифичность и обладает свойствами суперантигена. Антитела к М-антигену обладают защитными свойствами (антитела к Т- и Rбелкам такими свойствами не обладают). М- подобные белки обнаружены у стрептококков групп С и G. Возможно, они являются для них факторами патогенности. • Капсула - второй по значимости фактор вирулентности. Она защищает бактерии от антимикробного потенциала фагоцитов и облегчает адгезию к эпителию. В ее состав входит гиалуроновая кислота, аналогичной той, которая входит в состав ткани человека, поэтому фагоциты не распознают стрептококки, имеющие капсулу, как чужеродные антигены. Капсула маскирует от них стрептококки. Интерес представляет способность бактерий самостоятельно разрушать капсулу при инвазии в ткани за счёт синтеза гиалуронидазы. Роль гиалуронидазы в патогенезе поражений изучена плохо: с одной стороны, она участвует в разрушении соединительнотканной стромы, с другой -- имеет сходство со многими аутоантигенами и, возможно, участвует в запуске аутоиммунных реакций.
 Факторы патогенности Streptococcus sp. Ферменты: Фактор, угнетающий хемотаксис (аминопептидаза), подавляет подвижность нейтрофильных фагоцитов. Гиалуронидаза - фактор инвазии. Фактор помутнения - гидролиз липопротеинов сыворотки крови. Протеиназа - разрушает коллаген, деструкция ткани эндокарда, разрушение различных белков; возможно, с ними связана тканевая токсичность. ДНК-азы(стрептодорназа) (А, В, С, D) - гидролиз ДНК Способность взаимодействовать с Fc-фрагментом Ig. G с помощью рецептора II - угнетение системы комплемента и активности фагоцитов.
Факторы патогенности Streptococcus sp. Ферменты: Фактор, угнетающий хемотаксис (аминопептидаза), подавляет подвижность нейтрофильных фагоцитов. Гиалуронидаза - фактор инвазии. Фактор помутнения - гидролиз липопротеинов сыворотки крови. Протеиназа - разрушает коллаген, деструкция ткани эндокарда, разрушение различных белков; возможно, с ними связана тканевая токсичность. ДНК-азы(стрептодорназа) (А, В, С, D) - гидролиз ДНК Способность взаимодействовать с Fc-фрагментом Ig. G с помощью рецептора II - угнетение системы комплемента и активности фагоцитов.
 Факторы патогенности Streptococcus sp. Токсины: Эритрогенин - вызывает появление сыпи, которая наблюдается при скарлатине. Скарлатину могут вызвать только те штаммы, которые вырабатывают эритрогенный токсин за счет присутствия умеренного фагового генома. Обладает цитотоксическим, пирогенным, симпатикотропным, аллергическим действием Эритрогенный токсин обладает антигенной активностью, вызывая у людей образование специфического антитоксина, который нейтрализует токсин. У людей, имеющих в организме антитела к эритрогенному токсину (антитоксины), сыпь не образуется, хотя они остаются восприимчивыми к стрептококковой инфекции. Гемолизин О (стрептолизин О) разрушает эритроциты, обладает цитотоксическим, в том числе лейкотоксическим и кардиотоксическим, действием, его образуют большинство стрептококков серогрупп А, С и G. Гемолизин S (стрептолизин S). Стрептолизин S продуцируют преимущественно стрептококки группы А. Иммуносупрессорное действие. Стрептолизины - S и О, являются лейкоцидином и гемолизином. Прозрачная зона, образующаяся вокруг колоний стрептококка - это результат комбинированного действия обоих гемолизинов: Стрептолизин О чувствителен к кислороду и хорошо растворим в воде (диффундирует в среду), поэтому он действует под колонией, в толще агара, где условия анаэробные. Стрептолизин S устойчив к кислороду и потому вызывает поверхностный гемолиз. Поскольку стрептолизин О (но не S) обладает иммуногенными свойствами, антитела к нему (анти-0 стрептолизин) являются следствием стрептококковой инфекции и их определение используется в диагностике. Титр антистрептолизина О (ASO) в сыворотке более 160 -200 ЕД считают патологически высоким. Это указывает или на недавно перенесенную стрептококковую инфекцию или на хронический процесс. Стрептокиназа (фибринолизин) - активатор фермента, расщепляющего фибрин и другие белки (основные белки сгустков крови). Свертывание крови играет важную роль в заживлении ран, так как оно ограничивает распространение местной инфекции. Стрептокиназа, являясь важным фактором вирулентности, благодаря своему прямому действию способствует распространению инфекции и возникновению генерализованных форм.
Факторы патогенности Streptococcus sp. Токсины: Эритрогенин - вызывает появление сыпи, которая наблюдается при скарлатине. Скарлатину могут вызвать только те штаммы, которые вырабатывают эритрогенный токсин за счет присутствия умеренного фагового генома. Обладает цитотоксическим, пирогенным, симпатикотропным, аллергическим действием Эритрогенный токсин обладает антигенной активностью, вызывая у людей образование специфического антитоксина, который нейтрализует токсин. У людей, имеющих в организме антитела к эритрогенному токсину (антитоксины), сыпь не образуется, хотя они остаются восприимчивыми к стрептококковой инфекции. Гемолизин О (стрептолизин О) разрушает эритроциты, обладает цитотоксическим, в том числе лейкотоксическим и кардиотоксическим, действием, его образуют большинство стрептококков серогрупп А, С и G. Гемолизин S (стрептолизин S). Стрептолизин S продуцируют преимущественно стрептококки группы А. Иммуносупрессорное действие. Стрептолизины - S и О, являются лейкоцидином и гемолизином. Прозрачная зона, образующаяся вокруг колоний стрептококка - это результат комбинированного действия обоих гемолизинов: Стрептолизин О чувствителен к кислороду и хорошо растворим в воде (диффундирует в среду), поэтому он действует под колонией, в толще агара, где условия анаэробные. Стрептолизин S устойчив к кислороду и потому вызывает поверхностный гемолиз. Поскольку стрептолизин О (но не S) обладает иммуногенными свойствами, антитела к нему (анти-0 стрептолизин) являются следствием стрептококковой инфекции и их определение используется в диагностике. Титр антистрептолизина О (ASO) в сыворотке более 160 -200 ЕД считают патологически высоким. Это указывает или на недавно перенесенную стрептококковую инфекцию или на хронический процесс. Стрептокиназа (фибринолизин) - активатор фермента, расщепляющего фибрин и другие белки (основные белки сгустков крови). Свертывание крови играет важную роль в заживлении ран, так как оно ограничивает распространение местной инфекции. Стрептокиназа, являясь важным фактором вирулентности, благодаря своему прямому действию способствует распространению инфекции и возникновению генерализованных форм.
 Стрептококки серогруппы А • S. pyogenes • гноеродно-гемолитические, этиологическая причина возникновения ангины, эндокардита, ревматизма, гломерулонефрита, рожистого воспаления, родового сепсиса, фарингита и скарлатины.
Стрептококки серогруппы А • S. pyogenes • гноеродно-гемолитические, этиологическая причина возникновения ангины, эндокардита, ревматизма, гломерулонефрита, рожистого воспаления, родового сепсиса, фарингита и скарлатины.
 Скарлатина • От итал. skarlato – красный, багровый • Инфекционное токсико-септическое заболевание, сопровождающееся лихорадочным состоянием и ангиной (часто некротической), увеличением лимфоузлов, ярко-красной мелкоточечной сыпью, мощной интоксикацией организма.
Скарлатина • От итал. skarlato – красный, багровый • Инфекционное токсико-септическое заболевание, сопровождающееся лихорадочным состоянием и ангиной (часто некротической), увеличением лимфоузлов, ярко-красной мелкоточечной сыпью, мощной интоксикацией организма.
 Основной путь передачи S. pyogenes Воздушно-капельный, через слизистую оболочку носоглотки. Инкубационный период от 1 -12 дней. Развиваются в миндалинах, выделяют токсины, которые попадая в кровь, вызывают общую интоксикацию организма с последующей аллергизацией и осложнениями в виде артритов и нефрита. Первоначальный диагноз ставят по клиническим данным.
Основной путь передачи S. pyogenes Воздушно-капельный, через слизистую оболочку носоглотки. Инкубационный период от 1 -12 дней. Развиваются в миндалинах, выделяют токсины, которые попадая в кровь, вызывают общую интоксикацию организма с последующей аллергизацией и осложнениями в виде артритов и нефрита. Первоначальный диагноз ставят по клиническим данным.
 Кожная проба Дика (G. Н. and G. F. Dick амер. батериологи) • внутрикожный тест на присутствие в организме АТ к эритрогенному токсину S. pyogenes (скарлатина). • Для постановки пробы Дика внутрь кожи ладонной поверхности предплечья вводят 0, 1 мл стандартного эритрогенного токсина. • За положительную реакцию принимают появление через 1 - 4 ч на месте введения токсина воспалительного инфильтрата диаметром в 10 мм и более. • Положительная проба указывает на восприимчивость человека к скарлатине, отрицательная - на наличие иммунитета .
Кожная проба Дика (G. Н. and G. F. Dick амер. батериологи) • внутрикожный тест на присутствие в организме АТ к эритрогенному токсину S. pyogenes (скарлатина). • Для постановки пробы Дика внутрь кожи ладонной поверхности предплечья вводят 0, 1 мл стандартного эритрогенного токсина. • За положительную реакцию принимают появление через 1 - 4 ч на месте введения токсина воспалительного инфильтрата диаметром в 10 мм и более. • Положительная проба указывает на восприимчивость человека к скарлатине, отрицательная - на наличие иммунитета .
 АМ препараты при скарлатине • пенициллин • ванкомицин • эритромицин
АМ препараты при скарлатине • пенициллин • ванкомицин • эритромицин
 Стрептококки серогруппы В • S. agalactiae • Обнаруживают на слизистых оболочках глотки, прямой кишки, гениталий, • у 25% здоровых женщин – бессимптомные носители, но в дальнейшем это может привести к септическому аборту, родовому сепсису, сепсису новорожденных и менингиту новорожденных.
Стрептококки серогруппы В • S. agalactiae • Обнаруживают на слизистых оболочках глотки, прямой кишки, гениталий, • у 25% здоровых женщин – бессимптомные носители, но в дальнейшем это может привести к септическому аборту, родовому сепсису, сепсису новорожденных и менингиту новорожденных.
 Стрептококки серогрупп С и G • S. equi, • S. zooepidermicus • Комменсалы мочевыводящих путей и урогенитального тракта, но при определенных обстоятельствах могут вызывать заболевания.
Стрептококки серогрупп С и G • S. equi, • S. zooepidermicus • Комменсалы мочевыводящих путей и урогенитального тракта, но при определенных обстоятельствах могут вызывать заболевания.
 Стрептококки серогруппы D • В основном – энтерококки • Обитатели кишечника здорового человека, • но при определенных условиях могут стать причиной развития послеоперационных осложнений, пиелонефрита, бактериального эндокардита, язв при пролежнях и абсцессов различной локализации.
Стрептококки серогруппы D • В основном – энтерококки • Обитатели кишечника здорового человека, • но при определенных условиях могут стать причиной развития послеоперационных осложнений, пиелонефрита, бактериального эндокардита, язв при пролежнях и абсцессов различной локализации.
 Стрептококки, не содержащие групповой АГ • S. mutans – обитатель полости рта, частая причина кариеса, абсцессов, болезней пародонта. • S. pneumoniae - пиогенные стрептококки, причина пневмонии, отличаются от остальных стрептококков особыми свойствами.
Стрептококки, не содержащие групповой АГ • S. mutans – обитатель полости рта, частая причина кариеса, абсцессов, болезней пародонта. • S. pneumoniae - пиогенные стрептококки, причина пневмонии, отличаются от остальных стрептококков особыми свойствами.
 Лабораторная диагностика при стрептококковых инфекциях По двум направлениям: • Выделение чистой культуры с последующей идентификацией • Определение напряженности иммунитета. • При острых инфекциях достаточно выделения возбудителя. • При хронических – определение АТ в сыворотке крови.
Лабораторная диагностика при стрептококковых инфекциях По двум направлениям: • Выделение чистой культуры с последующей идентификацией • Определение напряженности иммунитета. • При острых инфекциях достаточно выделения возбудителя. • При хронических – определение АТ в сыворотке крови.
 Выделение чистой культуры стрептококков с последующей идентификацией (4 сут. ) • 1 сут. – посев материала и бактериоскопия • 2 сут. – изучение характера колоний (выявляют мелкие 0, 51 мм, серые, полупрозрачные) и отсев на получение чистой культуры • 3 сут. – получена чистая культура на ППС, ставят тесты: каталаза (-) - главный тест, исследование характера роста в ЖПС – придонно-пристеночный рост (т. к. образует цепочки). Посев на чувствительность к АМ препаратам • 4 сут. – окончательная идентификация
Выделение чистой культуры стрептококков с последующей идентификацией (4 сут. ) • 1 сут. – посев материала и бактериоскопия • 2 сут. – изучение характера колоний (выявляют мелкие 0, 51 мм, серые, полупрозрачные) и отсев на получение чистой культуры • 3 сут. – получена чистая культура на ППС, ставят тесты: каталаза (-) - главный тест, исследование характера роста в ЖПС – придонно-пристеночный рост (т. к. образует цепочки). Посев на чувствительность к АМ препаратам • 4 сут. – окончательная идентификация
 Заболевания • • • Ангина Рожистое воспаление Скарлатина Эндокардит Ревматизм Гломерулонефрит Родовой сепсис Фарингит Тонзиллит
Заболевания • • • Ангина Рожистое воспаление Скарлатина Эндокардит Ревматизм Гломерулонефрит Родовой сепсис Фарингит Тонзиллит
 Заболевания, вызываемые стрептококками группы А • К первичным формам относят стрептококковые поражения ЛОР-органов (ангины, фарингиты, ОРВИ, отиты и др. ), кожи (импетиго, эктиму), скарлатину, рожу. • Среди вторичных форм выделены заболевания с аутоиммунным механизмом (негнойные заболевания) и заболевания, при которых аутоиммунный механизм не выявлен (токсикосептические). • - Вторичные формы с аутоиммунным механизмом развития - ревматизм, гломерулонефрит, васкулиты. • - Вторичные формы без аутоиммунного компонента - метатонзиллярный и перитонзиллярный абсцессы, некротические поражения мягких тканей, септические осложнения. • К редким формам причислены некротические фасциит и миозит, энтерит, очаговые поражения внутренних органов, синдром токсического шока, сепсис и др.
Заболевания, вызываемые стрептококками группы А • К первичным формам относят стрептококковые поражения ЛОР-органов (ангины, фарингиты, ОРВИ, отиты и др. ), кожи (импетиго, эктиму), скарлатину, рожу. • Среди вторичных форм выделены заболевания с аутоиммунным механизмом (негнойные заболевания) и заболевания, при которых аутоиммунный механизм не выявлен (токсикосептические). • - Вторичные формы с аутоиммунным механизмом развития - ревматизм, гломерулонефрит, васкулиты. • - Вторичные формы без аутоиммунного компонента - метатонзиллярный и перитонзиллярный абсцессы, некротические поражения мягких тканей, септические осложнения. • К редким формам причислены некротические фасциит и миозит, энтерит, очаговые поражения внутренних органов, синдром токсического шока, сепсис и др.
 Стрептококковая ангина. Лопнувшие нагноившиеся фолликулы и фибринозные налеты образовали плотную пленку.
Стрептококковая ангина. Лопнувшие нагноившиеся фолликулы и фибринозные налеты образовали плотную пленку.
 Стрептококковая ангина. Фолликулы и фибринозные налеты образовали плотную пленку.
Стрептококковая ангина. Фолликулы и фибринозные налеты образовали плотную пленку.
 Стрептококковая ангина. Некротические изменения в тканях и биопленки.
Стрептококковая ангина. Некротические изменения в тканях и биопленки.
 Инфекции, вызываемые стрептококками группы В • Относящиеся к серогруппе В стрептококки представляют особый интерес для ветеринаров из-за их связи с маститом у крупного рогатого скота, что послужило основанием для их видового названия: S. agalactiae. Этот бета-гемолитический микроорганизм обычно, хотя и не всегда, устойчив к бацитрацину. Он может быть идентифицирован по характерному содержанию в стенке углеводов группы В, но и с помощью биохимических реакций, позволяющих установить выработку ими гиппуриказы и так называемого фактора CAMP, а также по неспособности гидролизировать желчеэскулиновый агар. Учитывая присутствие поверхностных полисахаридов и белковых антигенов, стрептококки группы В могут быть подразделены на 5 серотипов: la, Ib, Ic, II и III. • Человеческие штаммы стрептококков группы В, очевидно, отличающиеся биологически от штаммов, полученных от крупного рогатого скота, часто обитают в женских половых путях и на слизистых оболочках глотки и прямой кишки. Бессимптомные их носители, женщины детородного возраста, составляют 6 --25%
Инфекции, вызываемые стрептококками группы В • Относящиеся к серогруппе В стрептококки представляют особый интерес для ветеринаров из-за их связи с маститом у крупного рогатого скота, что послужило основанием для их видового названия: S. agalactiae. Этот бета-гемолитический микроорганизм обычно, хотя и не всегда, устойчив к бацитрацину. Он может быть идентифицирован по характерному содержанию в стенке углеводов группы В, но и с помощью биохимических реакций, позволяющих установить выработку ими гиппуриказы и так называемого фактора CAMP, а также по неспособности гидролизировать желчеэскулиновый агар. Учитывая присутствие поверхностных полисахаридов и белковых антигенов, стрептококки группы В могут быть подразделены на 5 серотипов: la, Ib, Ic, II и III. • Человеческие штаммы стрептококков группы В, очевидно, отличающиеся биологически от штаммов, полученных от крупного рогатого скота, часто обитают в женских половых путях и на слизистых оболочках глотки и прямой кишки. Бессимптомные их носители, женщины детородного возраста, составляют 6 --25%
 Чувствительность стрептококков к АМП • 1 -й ряд – пенициллин, цефалоспорин 2 -й ряд – ванкомицин, эритромицин
Чувствительность стрептококков к АМП • 1 -й ряд – пенициллин, цефалоспорин 2 -й ряд – ванкомицин, эритромицин
 Эпидемиология • За год регистрируется около 12 миллионов случаев гнойноинфекционных поражений слизистых оболочек и кожи по вине стрептококков. При отсутствии лечения такая инфекция может привести к развитию ревматизма с последующим формированием ревматического порока сердца. • Ревматоидные состояния регистрируют у 10 миллионов человек, приводя к гибели 400 тысяч пациентов. • Благодаря лечению антибиотиками в развитых странах ревматизм стал встречаться реже. • Остро стоит вопрос о вакцине, гораздо дешевле предупреждать ревматизм и др. заболевания, чем их лечить.
Эпидемиология • За год регистрируется около 12 миллионов случаев гнойноинфекционных поражений слизистых оболочек и кожи по вине стрептококков. При отсутствии лечения такая инфекция может привести к развитию ревматизма с последующим формированием ревматического порока сердца. • Ревматоидные состояния регистрируют у 10 миллионов человек, приводя к гибели 400 тысяч пациентов. • Благодаря лечению антибиотиками в развитых странах ревматизм стал встречаться реже. • Остро стоит вопрос о вакцине, гораздо дешевле предупреждать ревматизм и др. заболевания, чем их лечить.
 Препараты • Стрептокиназа • Бета-гемолитический стрептококк группы А помимо других факторов патогенности вырабатывает белок стрептокиназу, который растворяет тромбы и позволяет бактерии распространяться по организму больного. На основе стрептокиназы в отечественной медицине применяется препарат для восстановления кровотока в затромбировавшемся сосуде при остром инфаркте миокарда, однако он обладает высокой аллергенностью и способен приводить к тяжелым аллергическим реакциям, особенно при повторном применении.
Препараты • Стрептокиназа • Бета-гемолитический стрептококк группы А помимо других факторов патогенности вырабатывает белок стрептокиназу, который растворяет тромбы и позволяет бактерии распространяться по организму больного. На основе стрептокиназы в отечественной медицине применяется препарат для восстановления кровотока в затромбировавшемся сосуде при остром инфаркте миокарда, однако он обладает высокой аллергенностью и способен приводить к тяжелым аллергическим реакциям, особенно при повторном применении.
 Препараты • Актилизе • В мировой практике вместо стрептокиназы применяется, например, альтеплаза (актилизе) — рекомбинантный препарат (полученный с помощью генной инженерии). Он безопаснее и дает меньше побочных эффектов, но стоит значительно дороже и потому используется редко.
Препараты • Актилизе • В мировой практике вместо стрептокиназы применяется, например, альтеплаза (актилизе) — рекомбинантный препарат (полученный с помощью генной инженерии). Он безопаснее и дает меньше побочных эффектов, но стоит значительно дороже и потому используется редко.
 Профилактика и лечение • ИРС-19 • Препарат ИРС-19 представляет собой вакцину для распыления в нос, содержит антигены к ряду видов стрептококка. • • • • Из 100 мл препарата 43, 27 мл составляют лизаты бактерий, в том числе: Золотистый стафилококк — 9, 99 мл Пневмококк тип I, III, V, VIII, XII — по 1, 11 мл Streptococcus pyogenes group A — 1, 66 мл Streptococcus dysgalactiae group C — 1, 66 мл Streptococcus group G — 1, 66 мл Enterococcus faecium — 0, 83 мл Enterococcus faecalis — 0, 83 мл Neisseria subflava — 2, 22 мл Neisseria perflava — 2, 22 мл Klebsiella pneumoniae — 6, 66 мл Moraxella catarrhalis — 2, 22 мл Haemophilus influenzae тип B — 3, 33 мл Acinetobacter calcoaceticus — 3, 33 мл • Таким образом, ИРС-19 защищает от стафилококка, стрептококков, пневмококков и энтерококков. Применение в нос обеспечивает усиление местного иммунитета путем образования секреторных иммуноглобулинов класса A (s. Ig. A) и неспецифическую защиту путем активации макрофагов. Применение ИРС-19 защищает организм от бактериальных (гнойных) осложнений простуд. При этом частота ОРВИ практически не изменяется, т. к. ИРС-19 не содержит вирусных частиц, но ОРВИ будут протекать заметно легче.
Профилактика и лечение • ИРС-19 • Препарат ИРС-19 представляет собой вакцину для распыления в нос, содержит антигены к ряду видов стрептококка. • • • • Из 100 мл препарата 43, 27 мл составляют лизаты бактерий, в том числе: Золотистый стафилококк — 9, 99 мл Пневмококк тип I, III, V, VIII, XII — по 1, 11 мл Streptococcus pyogenes group A — 1, 66 мл Streptococcus dysgalactiae group C — 1, 66 мл Streptococcus group G — 1, 66 мл Enterococcus faecium — 0, 83 мл Enterococcus faecalis — 0, 83 мл Neisseria subflava — 2, 22 мл Neisseria perflava — 2, 22 мл Klebsiella pneumoniae — 6, 66 мл Moraxella catarrhalis — 2, 22 мл Haemophilus influenzae тип B — 3, 33 мл Acinetobacter calcoaceticus — 3, 33 мл • Таким образом, ИРС-19 защищает от стафилококка, стрептококков, пневмококков и энтерококков. Применение в нос обеспечивает усиление местного иммунитета путем образования секреторных иммуноглобулинов класса A (s. Ig. A) и неспецифическую защиту путем активации макрофагов. Применение ИРС-19 защищает организм от бактериальных (гнойных) осложнений простуд. При этом частота ОРВИ практически не изменяется, т. к. ИРС-19 не содержит вирусных частиц, но ОРВИ будут протекать заметно легче.


